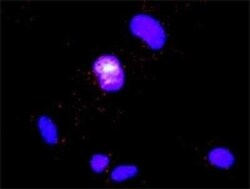
DOCK2 Antibody (2F4), Novus Biologicals 0.1 mg | Buy Online | Novus Biologicals | Fisher Scientific

missing translation for 'onlineSavingsMsg'
Learn More
Learn More
Description
DOCK2 Monoclonal antibody specifically detects DOCK2 in Human samples. It is validated for ELISA, Proximity Ligation Assay

Specifications
Specifications
| Antigen | DOCK2 |
| Applications | ELISA, Proximity Ligation Assay |
| Classification | Monoclonal |
| Clone | 2F4 |
| Conjugate | Unconjugated |
| Formulation | In 1x PBS, pH 7.4 |
| Gene Accession No. | AAH16996 |
| Gene Alias | dedicator of cytokinesis 2, dedicator of cytokinesis protein 2, FLJ46592, KIAA0209dedicator of cyto-kinesis 2 |
| Host Species | Mouse |
| Immunogen | DOCK2 (AAH16996, 1 a.a. ~ 336 a.a) full-length recombinant protein with GST tag. MW of the GST tag alone is 26 KDa. MCVCAEDGKTLPVAVPIEDMQRIHLRFMFRHRSSLESKDKGEKNFAMSYVKLMKEDGTTLHDGFHDLVVLKGDSKKMEDASAYLTLPSYRHHVENKGATLSRSSSSVGGLSVSSRDVFSISTLVCSTKLTQNVGLLGLLKWRMKPQLEESMRRLFESINNLMKSQYKTTILLQVAALKYIPSVLHDVEMVFDAKLLSQLLYEFYTCIPPVKLQKQKVQSMNEIVQSNLFKKQECRDILLPVITKELKELLEQKDDMQHQVLERKYCVELLNSILEVLSYQDAAFTYHHIQEIMVQLLRTVNRTVITMGRDHILIGACCNCGFPSSTPHSLIQWLWG |
| Show More |
Product Title
By clicking Submit, you acknowledge that you may be contacted by Fisher Scientific in regards to the feedback you have provided in this form. We will not share your information for any other purposes. All contact information provided shall also be maintained in accordance with our Privacy Policy.
Spot an opportunity for improvement?